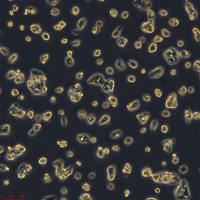
HepG2细胞敲除ALB基因细胞系

相关产品推荐更多 >
万千商家帮你免费找货
0 人在求购买到急需产品
- 详细信息
- 技术资料
细胞名称:OSUMMER.13 Mouse NRAS-Mutant Melanoma Cell Line
货号:SCC457
规格:vial of ≥1x10˄6 cells
应用:Cells are tested negative for infectious diseases by a Mouse Essential CLEAR Panel and have been found to be negative for all pathologies in this test.
Cells are verified to be of mouse origin and negative for interspecies contamination from rat, human, Chinese hamster, Golden Syrian hamster, and non-human primate (NHP) as assessed by a Contamination Clear panel.
Cells are negative for mycoplasma contamination.
Cells are genotyped by STR analysis to verify the unique identity of the cell line.
特点和优势:This OSUMMER.13 female mouse NRAS-mutant cell line is a UV-accelerated model for melanoma obtained from the TN model of mouse melanoma. This model is syngeneic with the C57BL/6 mouse model. OSUMMER cells can form tumors in vivo without Matrigel injection.
储存及稳定性:OSUMMER.13 cells should be stored in liquid nitrogen until use. The cells can be cultured for at least 10 passages after initial thawing without significantly affecting the cell marker expression and functionality.
其他说明:This product is intended for sale and sold solely to academic institutions for internal academic research use per the terms of the “Academic Use Agreement” as detailed in the product documentation.
风险提示:丁香通仅作为第三方平台,为商家信息发布提供平台空间。用户咨询产品时请注意保护个人信息及财产安全,合理判断,谨慎选购商品,商家和用户对交易行为负责。对于医疗器械类产品,请先查证核实企业经营资质和医疗器械产品注册证情况。